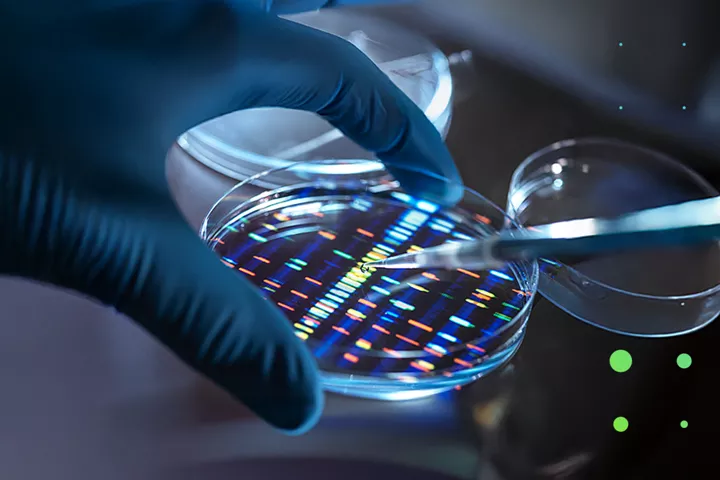

Life Sciences & Health Care
Rapid transformation in the life sciences and health care industry can require businesses to strike a balance between patient demands, market potential and policy compliance, while continuing to innovate. We create solutions that can help you to remain competitive in this constantly evolving market.
Where impact happens
Innovation is blurring the traditional boundaries in the life sciences and health care industry. Our extensive industry experience, differentiated market research, data and insights give us a comprehensive understanding of the opportunities and challenges of the changing health care ecosystem.
We are positioned to help you to drive your business forward—not only because we understand complex problems, but because we have the skills, tools and multi-disciplinary solutions to help solve them. Through deep understanding of our vision of the Future of Health™, health equity and digital transformation, we can help you navigate the industry’s transformation as exponential innovation propels health care to the future.

Our Thinking
Securing trust in the global supply chain of COVID-19 vaccines
The critical success factors identified in 2020 remain paramount. But now stakeholders need to act on the lessons learnt to strengthen the collective ability to respond to or—better yet—proactively address the existing global health Issue.
The promise of digital mental health in a meta world
A Deloitte and World Economic Forum report